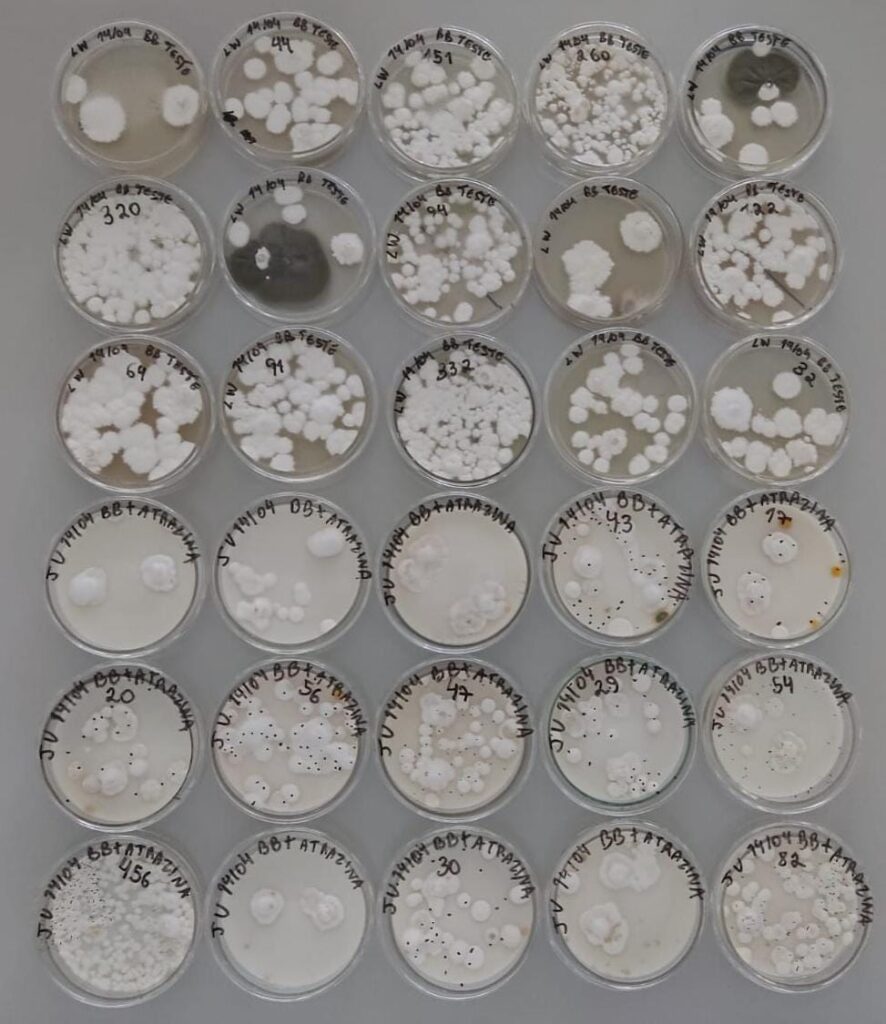
testes

Nós somos o CRIVO. O veredito final para a sua mistura.
Não aposte na sua calda. Tenha o laudo.
Análises científicas para testar a compatibilidade e viabilidade das suas misturas de pulverização.
(14) 99722-9840
Bem vindos
Sobre nós
A CRIVOM nasceu da união dos projetos de pesquisa BioMix e AgroMix do LMPP para trazer maior segurança da ciência para dentro do seu tanque. Nós analisamos sua mistura antes que ela vá a campo.
No BioMix realizamos testes para avaliar o impacto da presença de um defensivo químico sobre um agente de controle biológico e no AgroMix avaliamos a compatibilidade físico-química para garantir uma calda adequadra.
Razão para
Fazer parceria de pesquisa conosco
Especialistas
Com formação e know-how no assunto e contamos com rede de suporte com instituições de renome como o Instituto Biológico de São Paulo e Campinas, UNIARA e IFSP.
Pesquisa de qualidade
Somos uma startup de base científica (deep tech) com a missão de preencher a lacuna entre a pesquisa acadêmica e as soluções práticas para o campo.
